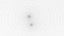
Moon

Formats (2)
Native
|
3ds Max
2021
|
Default Scanline
3ds Max
2021
|
Default Scanline
Specifications
Publish Date
January 28, 2022
Product ID
1846836
Polygons
39,600
Vertices
19,802
Polygonal
Textures
Materials
TurboSquid Exclusive

1428 Products
|
Contributor Since 2020
Have questions? Chat with us now.